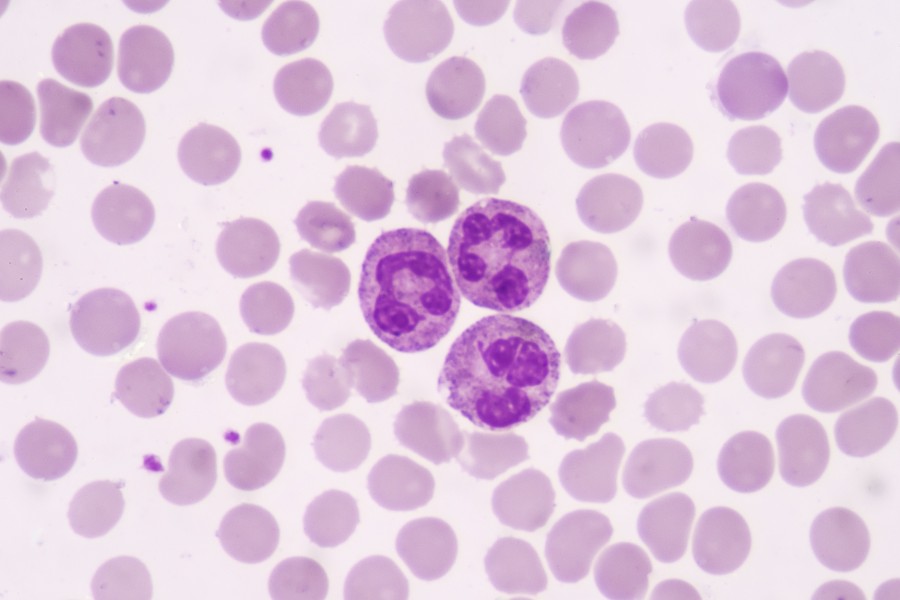
Neutrofile poniżej normy. Jakie są przyczyny?

- Polecane
- Endokrynologia
- Okulistyka
- Ortopedia
- Stomatologia
- Alergologia
- Kardiologia
- Ginekologia
- Dermatologia
- Neurologia
- Laryngologia
- Urologia
- Pulmonologia
- Diabetologia
- Zdrowie
- Odżywianie i Diety
- Pediatria
- Badania i diagnostyka
- proktologia
- Psychiatria i psychologia
- Reumatologia
- Hematologia
- Onkologia
- Chirurgia
- Czasopismo OSOZ
- Nefrologia
- Gastrologia
- Medycyna estetyczna
Neutrofile poniżej normy. Jakie są przyczyny?
- Publikacja:
- 2019-08-01 09:00
- Aktualizacja:
- 2023-12-06 11:26
Czym są neutrofile? Jakie są ich podstawowe funkcje w organizmie? Jakie są przyczyny obniżonego i podwyższonego poziomu neutrofili we krwi? Poznaj odpowiedzi na te pytania czytając poniższy wpis.
Neutrofile - czym są i jakie są ich funkcje?
Neutrofile są komórkami, które występują we krwi. Wraz z eozynofilami i bazofilami tworzą grupę granulocytów, które stanowią część białych krwinek, czyli leukocytów. Głównym zadaniem leukocytów jest obrona organizmu przed obcymi czynnikami, które wtargną do organizmu, np. bakterii, wirusów czy grzybów. Leukocyty rozpoznają także uszkodzone lub nieprawidłowo zbudowane komórki organizmu, np. komórki nowotworowe. Same neutrofile stanowią 40-75% leukocytów. Mają kształt kuli, o wymiarach około 12-15 mikrometrów.
Neutrofile pełnią bardzo ważną rolę w naszym organizmie. Gdy zaczyna się zakażenie, głównie bakteryjne i grzybicze, biorą udział w obronie organizmu przed drobnoustrojami na drodze fagocytozy. Fagocytoza jest to pochłanianie zewnątrzkomórkowych makrocząsteczek przez granulocyty i ich trawienie, dzięki czemu szybko są zwalczane i usuwane. Drobnoustroje mają wówczas małe szanse na rozwinięcie zakażenia. Głównymi komórkami naszego organizmu, które są zdolne do fagocytozy, są m.in. monocyty i właśnie neutrofile. Neutrofile w walce wspomagają substancje, które uwalniane są przez ich ziarnistości: defensyny, laktoferyna, lizozym i mieloperoksydaza.
Neutrofile - norma
Aby sprawdzić poziom neutrofili wśród leukocytów, czyli wszystkich białych krwinek, przeprowadza się rozmaz krwi. Jest to badanie, w którym pod mikroskopem ogląda się próbkę krwi i ocenia wygląd oraz procentową ilość leukocytów, z podziałem na granulocyty, monocyty i limfocyty. Często lekarze pierwszego kontaktu zlecają to badanie, szczególnie gdy podejrzewają początek infekcji lub chcą sprawdzić jej przebieg.
Wartościami referencyjnymi w przypadku ilości neutrofili we krwi są:
- 1800–8000/μl - czyli liczba komórek na mikrolitr badanej krwi
- lub 60–70% - czyli procentowa ilość neutrofili wśród leukocytów (białych krwinek)
Obniżony poziom neutrofili
Neutropenia jest nazwą zjawiska niskiego poziomu granulocytów obojętnochłonnych we krwi. Najczęściej dochodzić może do niej w przypadku chemioterapii i radioterapii, stosowanych u pacjentów onkologicznych. Także choroby autoimmunologiczne mogą wywoływać neutropenię. Osoby cierpiące na niedokrwistość aplastyczną również mogą zauważyć obniżony poziom neutrofili na wynikach badań laboratoryjnych. Wszelkie infekcje wirusowe sprzyjają niskiemu poziomowi granulocytów obojętnochłonnych. Jeśli pacjent choruje na infekcję wirusową, np. odrę, różyczkę, zapalenie wątroby, dur, gruźlicę czy brucelozę, to z dużym prawdopodobieństwem wyniki badania krwi wskażą neutropenię. Także przyjmowanie niektórych leków może doprowadzić do niskiego poziomu neutrofili. Są to m.in. penicyliny, sulfonamidy, leki przeciwpadaczkowe, sole złota, allopurynol czy tyreostatyki. Neutropenię wywołaną przyjmowanymi lekami nazywamy neutropenią toksyczną lub alergiczną.

Podwyższony poziom neutrofili
W przypadku wyższego poziomu granulocytów obojętnochłonnych we krwi mówimy o neutrofilii. Najczęstszymi przyczynami tej dolegliwości są m.in. zakażenia bakteryjne, szczególnie ostre. Również reumatoidalne zapalenie stawów czy białaczki szpikowe mogą powodować zwiększenie poziomu granulocytów obojętnochłonnych. Osoby, które doświadczyły masywnej i nagłej utraty krwi także są predysponowane do neutrofilii. Nadmiar kortykosteroidów, powodowany m.in. przez nadczynność kory nadnerczy, terapię glikokortykosteroidami czy stres również może powodować niski poziom granulocytów obojętnochłonnych we krwi. Innymi przyczynami tej dolegliwości są m.in.: choroby metaboliczne, takie jak dna moczanowa, mocznica, kwasica ketonowa w przebiegu cukrzycy, przełom tarczycowy czy śpiączka wątrobowa. Zatrucia tlenkiem węgla i metalami ciężkimi, podobnie jak uszkodzenia tkanek niezwiązane z infekcjami (zawał mięśnia sercowego, zapalenie nerek, wrzodziejące zapalenie jelit) - także mogą powodować obniżenie poziomu neutrofili we krwi.
Neutrofile w ciąży
W ciąży wiele parametrów i wyników badań się zmienia. Nie zawsze oznacza to coś niepokojącego, ponieważ zmieniają się zazwyczaj tzw. zakresy referencyjne (normy). W przypadku poziomu neutrofili we krwi ciężarnej wyglądają one następująco:
- 2–7 x 10⁹/ l
- lub 37–80 proc. wszystkich krwinek białych
Po otrzymaniu wyników koniecznie trzeba udać się na wizytę do lekarza rodzinnego czy ginekologa i mu je pokazać. Zamiast wpadać w panikę i niepotrzebnie się denerwować, skosultujmy się z osobą, która biorąc pod uwagę nasz stan oraz inne czynniki, poprawnie zinterpretuje wartości widniejące na wynikach badania krwi.
Podsumowanie
Bardzo często przeprowadzenie badania krwi daje znak, że w naszym organizmie dzieje się coś niepokojącego. Także obserwacja granulocytów pozwala na uzyskanie wielu informacji dotyczących tego, co dzieje się w naszym ciele. Warto więc badać regularnie krew, a wszystkie wyniki najlepiej skonsultować z lekarzem. Dzięki portalowi LekarzeBezKolejki.pl w bardzo prosty sposób można zarezerwować wizytę zarówno u lekarza podstawowej opieki zdrowotnej, jak i specjalisty, i omówić wyniki wykonanego badania krwi.
Bibliografia:
- Gajewski P.: Interna Szczeklika 2018-2019, MP, Kraków 2018, wyd. 10
- Gołąb B., Traczyk W.: Anatomia i fizjologia człowieka, TUR, Łódź 1997, wyd. 1
- Crawford J., Dale D., Lyman G.: Chemotherapy‐induced neutropenia - Risks, consequences, and new directions for its management, Cancer, 2004, 100, 2
- Lamblin C., Gosset P., Tillie-Leblond I., Saulnier F., Marquette Ch.-H., Wallaert B., and A. B. Tonnel: Bronchial Neutrophilia in Patients with Noninfectious Status Asthmaticus, American Journal of Respiratory and Critical Care Medicine, 1998, 157
- Kuderer N., Dale D., Crawford J., Cosler L., Lyman G.: Mortality, morbidity, and cost associated with febrile neutropenia in adult cancer patients, Cancer, 2006, 106, 10
Autor
Redakcja lekarzebezkolejki.pl - W skład zespołu redakcyjnego portalu LekarzeBezKolejki.pl wchodzą wykwalifikowani farmaceuci. Ich bogate doświadczenie zawodowe i gruntowna wiedza nabyta na studiach farmaceutycznych umożliwiają tworzenie wiarygodnych i rzeczowych tekstów zgodnie z zasadami medycyny opartej na dowodach naukowych (EBM). Treści te są zawsze oparte na solidnych źródłach, takich jak aktualne badania naukowe czy specjalistyczne publikacje. Zespół łączy profesjonalizm z pasją do ciągłego rozwijania się i chęcią dzielenia się wiedzą, co przekłada się na atrakcyjne i wciągające materiały edukacyjne dla użytkowników.















